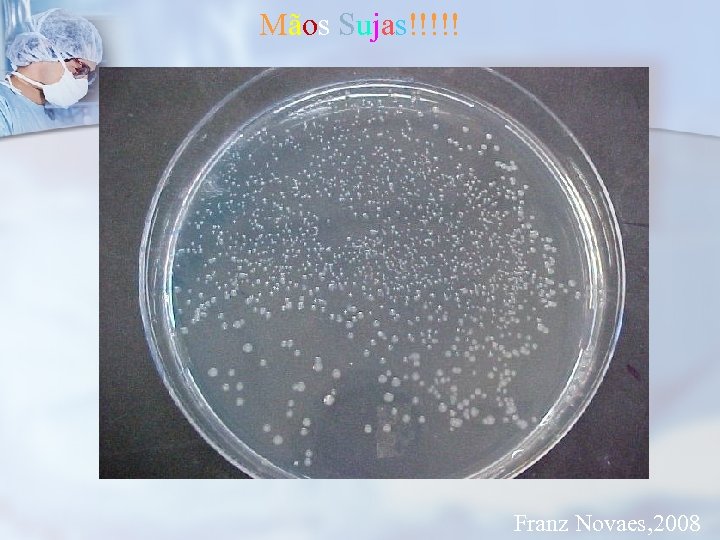
Mãos Sujas!!!!! Franz Novaes, 2008
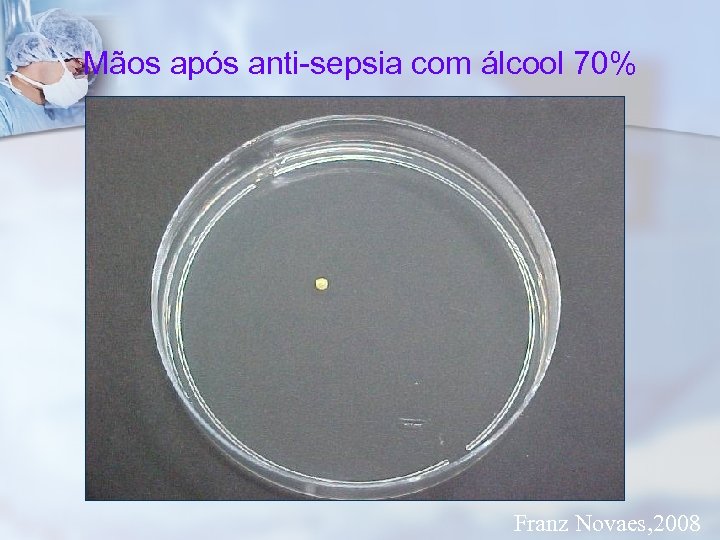
Mãos após anti-sepsia com álcool 70% Franz Novaes, 2008
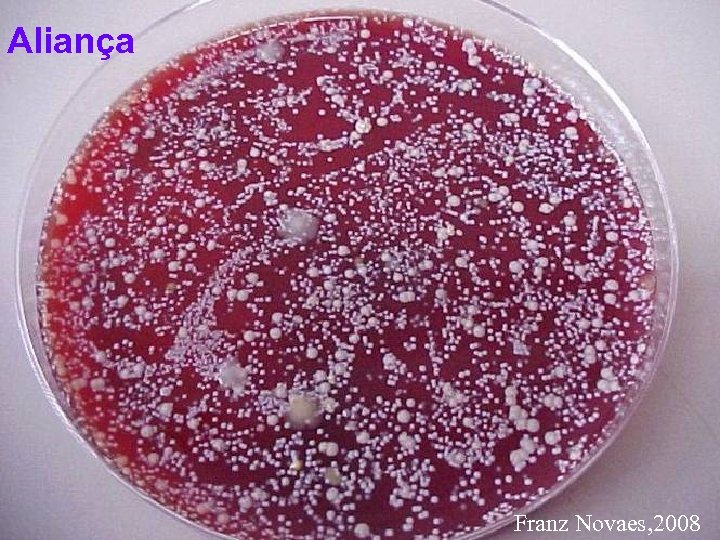
Aliança Franz Novaes, 2008
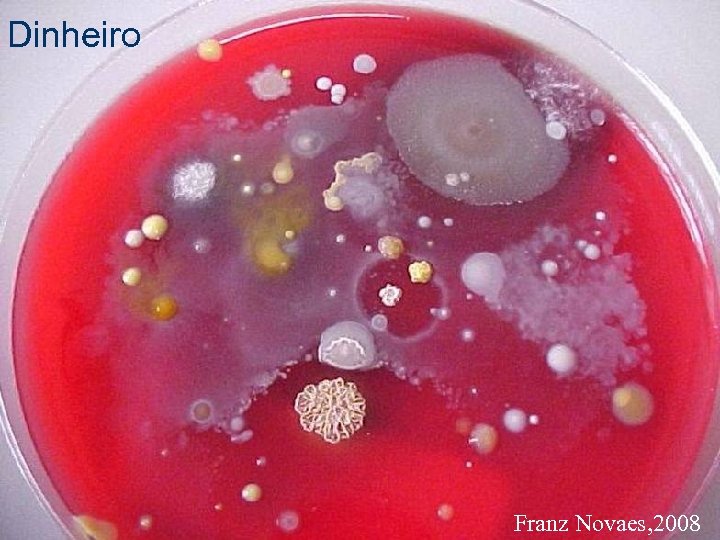
Dinheiro Franz Novaes, 2008
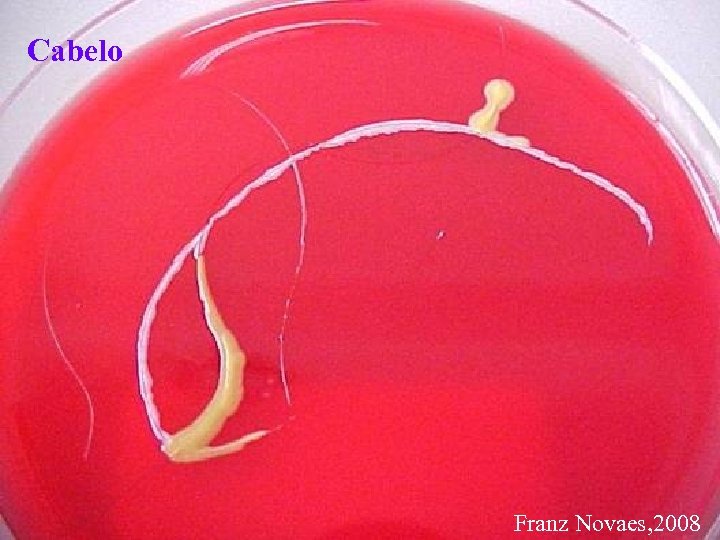
Cabelo Franz Novaes, 2008

638708ac5121bbc28d8b857df810cf8f.ppt
- Количество слайдов: 39

USO RACIONAL DE ANTIBIÓTICO! (quando usar? Quando suspender? Riscos!) AVANÇOS!! Paulo R. Margotto Prof. Curso de Medicina da Escola Superior de Ciências da Saúde (ESCS)/SES/DF Unidade de Neonatologia do Hospital Regional da Asa Sul www. paulomargotto. com. br, pmargotto@gmail. com VII Congresso Paraibano de Pediatria, João Pessoa (13 a 15/9/2012)

Uso Racional de Antibióticos Objetivo: evitar esta situação! Sepse por S. aureus

Uso Racional de Antibióticos Objetivo: evitar esta situação Sepse fúngica! Frankenbusch K et al, 2006

Uso Racional de Antibióticos Objetivo: evitar esta situação Enterocolite necrosante!

Uso Racional de Antibióticos n n n Sepse: Principal causa de admissão na UTI Neonatal e de morbimortalidade (países em desenvolvimento e desenvolvidos) Afeta 12 -40, 5/1000 nascidos vivos Mortalidade: 1, 5% (RN a termo)-40%(RN muito baixo peso) (responsável por 50% das mortes após 2 semanas de vida) Na ausência de marcadores específicos, muitos RN são tratados (desnecessariamente): 100% nos RN <1000 g!(culturas negativas!) Maior preocupação: antibioticoterapia profilática! (93% usam por 5 dias; 27 -85%≥ 5 dias!!!) Cotten, 2009; Yu, 2010; Alexander, 2011; Raimondi, 2011; Hofer, 2012

Uso Racional de Antibióticos Uso inadequado ou discutível de antibióticos n n n n RN pré - termo de muito baixo peso Rotura prematura de membranas Aspiração de mecônio Corioamnionite Febre materna Infecção do trato urinário materno RN com procedimentos invasivos (cateter vascular; ventilação: trocar circúito cada 7 dias ou mais) Prematuro “sem causa conhecida” Margotto, PR. Unid Neonatal, HRAS/ESCS

Uso Racional de Antibióticos Vamos procurar a causa do parto prematuro! FATORES DE RISCO q História obstétrica: parto prematuro anterior, abortamento q Estresse: baixo nível socio-econômico, solteiras, ansiedade, depressão, eventos funestos q Fadiga ocupacional q Distensão uterina excessiva: gestação gemelar, polidrâmnio q Fatores cervicais: comprimento cervical, , cirurgias prévias Amorim M, 2010 Margotto, PR. Unid Neonatal, HRAS/ESCS

Uso Racional de Antibióticos Vamos procurar a causa do parto prematuro! FATORES DE RISCO q Infecções: infecções sexualmente transmissíveis (chlamydia, gonorréia, tricomoníase), vaginose bacteriana, doença periodontal, infecção do trato urinário q Patologia placentária: placenta prévia, DPP, história de sangramento genital q Fatores fetais: anomalias fetais, restrição do crescimento fetal q Fatores genéticos: polimorfismos – fatores inflamatórios Amorim, M, 2010 Margotto, PR. Unid Neonatal, HRAS/ESCS

Uso Racional de Antibióticos Vamos procurar a causa do parto prematuro! FATORES DE RISCO q Tabagismo q Abuso de substâncias q Baixo nível educacional q Pré-natal inadequado q Extremos de idade materna q Extremos de peso (baixo peso, obesidade) Amorim M, 2010 Margotto, PR. Unid Neonatal, HRAS/ESCS

Uso Racional de Antibióticos Vamos procurar a causa do parto prematuro! História obstétrica e risco de parto prematuro História pregressa Risco de PP antes subsequente de 28 sem Nenhum PP anterior 9% 0, 23% 22% PP anterior < 28 sem 5% PP anterior 28 -34 sem 3% PP anterior 35 -36 sem 1% PP: parto prematuro Mercer, BM, Goldenberg, RL, Moawad, AH, Meis, PJ, et al. The preterm prediction study: effect of gestational age and cause of preterm birth on subsequent obstetric outcome. Am J Obstet Gynecol 1999; 181: 1216 -20 Amorim M, 2010 Margotto, PR. Unid Neonatal, HRAS/ESCS

Uso Racional de Antibióticos Vamos procurar a causa do parto prematuro! História obstétrica e risco de parto prematuro História pregressa Risco de PP 2 PP anteriores 42% Entre 32 e 36 semanas 33% Antes de 36 semanas 57% Gestação a termo seguida de PP 21% PP seguido de gestação a termo 13% 2 nascimentos anteriores a termo 5% PP: parto prematuro Mc. Manemy, J, Cooke, E, Amon, E, Leet, T. Recurrence risk for preterm delivery. Am J Obstet Gynecol 2007; 196: 576 -80 Margotto, PR. Unid Neonatal, HRAS/ESCS Amorim M, 2010

Uso Racional de Antibióticos Vamos procurar a causa do parto prematuro! n Periodontite (Inflamação destrutiva do periodonto (afeta aproximadamente 30% da mulheres na idade de procriar) n Infiltração bacteriana do periodonto n Toxinas bacterianas estimulam a resposta inflamatória crônica, com destruição do periodonto e formação de bolsas que tornam-se eventualmente infectadas n Pode induzir bacteremia recorrente, iniciando a produção de citocinas, prostaglandinas (PGE 2) e interleucinas (IL-6, IL-8) que podem afetar a gestação n Parece provável que a cascata inflamatória pode iniciar o trabalho de parto prematuro n a causa de RN de baixo peso: a PGE 2 restringe o fluxo placentário, causando necrose placentária e restrição do crescimento intra-uterino Silk H, 2008

Uso Racional de Antibióticos Vamos procurar a causa do parto prematuro! Periodontite Chambrone et al (2011) -metanálise de 11 estudos (todos os casos) parto prematuro (RR: 1, 70; IC a 95%: 1. 03 -2, 81) -metanálise de 3 estudos (periodontite moderada a severa) Parto prematuro (RR: 1, 96; IC a 95%: 1, 32 -2, 90) (alta heterogeneidade dos estudos!) Margotto, PR. Unid Neonatal, HRAS/ESCS

Uso Racional de Antibióticos Vamos procurar a causa do parto prematuro! Periodontite Margotto, PR. Unid Neonatal, HRAS/ESCS Chambrone et al, 2011

Uso Racional de Antibióticos Vamos procurar a causa do parto prematuro! Periodontite moderada a severa Margotto, PR. Unid Neonatal, HRAS/ESCS Chambrone et al, 2011

Uso Racional de Antibióticos Vamos procurar a causa do parto prematuro! Vaginose bacteriana : Desequilíbrio da flora vaginal normal com um supercrescimento de bactérias anaeróbicas (Gardnela vaginalis) e a falta da flora lactobacilar normal - Laxmi et al (2012): 37/152(24, 3%) pacientes em parto prematuro significante aumento de DMH (14 X 6%); VM ((14 X 5%); Internação e duração na UTI (15 X 6%) e 15% x 6%) - Mcdonald et al (2007): efeito do tratamento com antibiótico (15 estudos controlados; 588 mulheres)) antes de 20 semanas, redução do parto prematuro (OR= 0. 63, 95%; IC; 0. 48 to 0. 84; 5 ensaios, 2387 mulheres) - -história de parto prematuro, sem redução do parto prematuro (OR: 0. 83; 95% IC: 0. 59 to 1. 17, 5 ensaios, 622 mulheres) Margotto, PR. Unid Neonatal, HRAS/ESCS

Uso Racional de Antibióticos Quando iniciar antibiótico: RN assintomático com IG < 34 semanas com fatores clássicos - Bolsa rota > 24 h - ITU não tratada ou tratada < 72 h - Febre materna - Leucocitose materna - LA fétido ou purulento - Colonização materna pelo Streptococcus grupo ß - Gemelaridade (RN < 1000 g): 5 X risco de SGB - Hemograma, PCR, hemocultura - PCR diário (3 dias) INICIAR O ANTIBIÓTICO Margotto PR

Uso Racional de Antibióticos Delimitação da Idade Gestacional < 34 semanas n IG na qual inicia - se o aparecimento de substâncias protetoras no LA: n peptideos catiônicos, n Betalisina, n Complexo de zinco, n Transferina, n Todas peroxidase, as classes de imunoglobulinas Mataloun, 1997

Uso Racional de Antibióticos n RN assintomático com IG >34 semanas com ou sem fatores de risco clássicos: n Não iniciamos o antibiótico n Hemograma n PCR n. O com 12 - 24 - 48 h seriado (3 dias) hemograma não deve ser usado como o único parâmetro de decisão A decisão mais difícil: deve ser a RETIRADA Margotto PR

Uso Racional de Antibióticos n Iniciar o antibiótico se: n DMH* que não responde ao surfactante / cursa com hipotensão necessitando de drogas vasoativas n Acidose metabólica persistente n Hiperglicemia n Distermia n Má perfusão *DMH: doença da membrana hialina Margotto, PR.

Uso Racional de Antibióticos Flidel-Rimon O et al(2012): Israel Guidelines para detecção de sepse neonatal precoce n 2096 RN estudados (36, 8± 3, 8 sem) -(1662 assint 635 antib sepse em 1(0, 06%) n 434 sint 234 com fatores de riscos sepse em 20 (4, 6%) Mais de 99% dos RN assintomáticos foram expostos a antibioticoterapia intravenosa na ausência de infecção

Uso Racional de Antibióticos Fatores de risco-Poder preditivo 28 48 98 Flidel-Rimon O, 2012

Uso Racional de Antibióticos Parâmetros laboratoriais – poder preditivo 99 12 CBC: contagem completa do sangue (leucocitose >30. 000/mm 3; leucopenia <5000/mm 3 e plaquetopenia <150. 000/mm 3 Sem demonstração do valor clínico dos fatores de risco; o alto valor Preditivo negativo: prevenção da insônia induzida Pela ansiedade do neonatologista Flidel-Rimon O, 2012

Uso Racional de Antibióticos ) Antibioticoterapia empírica prolongada (≥ 5 dias; culturas negativas Patel, 2011: 50% sem bacteremia provada recebem tratamento para a sepse (situação diagnostica problemática!) n Cottom et al(2009): enterocolite necrosante e morte n 4039 RN<1000 g Regressão logística multivariada -Tempo prolongado de antibióticos altera o desenvolvimento fisiológico e imunológico intestinal enterocolite necrosante -Redução da flora bacteriana colonização por fungo candidíase neonatal

Uso Racional de Antibióticos ) Antibioticoterapia empírica prolongada (≥ 5 dias; culturas negativas n Alexandre et al (2011): estudo caso-controle (com e sem enterocolite necrosante-ECN) Após 1 -2 dias de exposição ao antibiótico, o risco de desenvolver ECN aumentou 1, 19 vezes e continuou a aumentar com a exposição adicional ao antibiótico ( 1, 43 para 3 -4 dias; 1, 71 para 5 -6 dias; 2, 05 para 7 -8 dias; 2, 45 para 9 a 10 dias e 2, 94 acima de 10 dias) Nos RN SEM SEPSE, A exposição ao antibiótico foi um risco significativamente independente para ECN

Uso Racional de Antibióticos ) n Kupala VS, 2011: 365 RN ≤ 32 sem; ≤ 1500 g Antibioticoterapia empírica prolongada (≥ 5 dias; culturas negativas n Regressão logística (controle de IG, peso, rotura prematura de membrana, vent mec, uso de leite materno para cada dia de antibioticoterapia empírica inicial, a odds ratio (OR) para sepse tardia, enterocolite necrosante ou morte e para sepse tardia, aumentou significativamente.

Uso Racional de Antibióticos O diagnóstico e tratamento de neonatos com suspeita de sepse de início precoce baseia-se em princípios científicos modificados pela "arte e experiência" do profissional A terapia antimicrobiana deve ser descontinuada em 48 horas em situações clínica em que a probabilidade da sepse é baixa. Artigo Integral! www. ncbi. nlm. nih. gov/pubmed/22547779 Polin RA; the COMMITTEE ON FETUS AND NEWBORN. Pediatrics. 2012 May; 129(5): 1006 -1015. Epub 2012 Apr 30.

Uso Racional de Antibióticos Ações de combate à Infecção na UTIN Lavagem das mãos: mãos sujas são mãos assassinas! Lavem as mãos!!!!!
Mãos Sujas!!!!! Franz Novaes, 2008

Mãos após lavagem com água e sabão Franz Novaes, 2008
Mãos após anti-sepsia com álcool 70% Franz Novaes, 2008
Aliança Franz Novaes, 2008

Pano de Limpeza Franz Novaes, 2008
Dinheiro Franz Novaes, 2008
Cabelo Franz Novaes, 2008

Mãos Sujas!!!!! Oelberg et al (2000) marcador de DNA no gancho do telefone n 8 horas após, 80% de amostras tinham o marcador a partir do telefone contaminado -locais mais consistentemente positivos para o marcador: os analisadores de gasometria, mouse do computador, telefone, prontuários médicos, ventiladores, botões de controle de calor radiante, monitores dos pacientes, e mãos das pessoas, sala de estar da Enfermagem, sala do café dos Staffs, área de estar dos Residentes Uma pessoa que contamina um equipamento tem um potencial de disseminar em toda a Unidade. Basta que uma pessoa não respeite as técnicas para causar um surto de infecção n

Uso Racional de Antibióticos LAVEM AS MÃOS! USEM ÁLCOOL A 70%

E AGORA? “Tudo parece impossível até que seja feito” (Nelson Mandela)

Obrigado pela atenção! www. paulomargotto. com. br pmargotto@gmail. com
638708ac5121bbc28d8b857df810cf8f.ppt